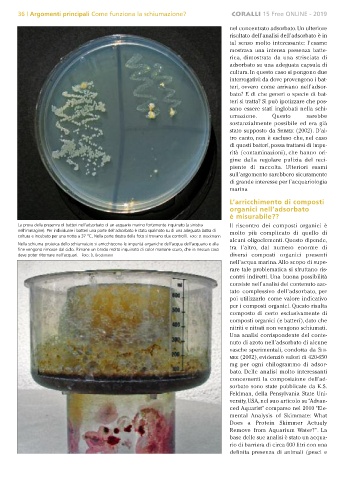

Page 38 - Rivista Coralli n.15 free
P. 38
36 | Argomenti principali Come funziona la schiumazione? CORALLI 15 Free ONLINE - 2019
nel concentrato adsorbato. Un ulteriore
risultato dell’analisi dell’adsorbato è in
tal senso molto interessante: l'esame
mostrava una intensa presenza batte-
rica, dimostrata da una strisciata di
adsorbato su una adeguata capsula di
cultura. In questo caso si pongono due
interrogativi: da dove provengono i bat-
teri, ovvero come arrivano nell’adsor-
bato? E di che generi o specie di bat-
teri si tratta? Si può ipotizzare che pos-
sano essere stati inglobati nella schi-
umazione. Questo sarebbe
sostanzialmente possibile ed era già
stato supposto da SHIMEK (2002). D’al-
tro canto, non è escluso che, nel caso
di questi batteri, possa trattarsi di impu-
rità (contaminazioni), che hanno ori-
gine dalla regolare pulizia del reci-
piente di raccolta. Ulteriori esami
sull’argomento sarebbero sicuramente
di grande interesse per l’acquariologia
marina
L’arricchimento di composti
organici nell’adsorbato
è misurabile??
La prova della presenza di batteri nell’adsorbato di un acquario marino fortemente inquinato (a sinistra Il riscontro dei composti organici è
nell’immagine). Per individuare i batteri una parte dell’adsorbato è stato spalmato su di una adeguata lastra di molto più complicato di quello di
coltura e incubato per una notte a 37 °C. Nella parte destra della foto si trovano due controlli. Foto: D. Brockmann
alcuni oligoelementi. Questo dipende,
Nella schiuma proteica dello schiumatoio si arricchiscono le impurità organiche dell’acqua dell’acquario e alla
fine vengono rimosse dal ciclo. Rimane un brodo molto inquinato di color marrone scuro, che in nessun caso tra l’altro, dal numero enorme di
deve poter ritornare nell’acquari. Foto: D. Brockmann diversi composti organici presenti
nell’acqua marina. Allo scopo di supe-
rare tale problematica si sfruttano ris-
contri indiretti. Una buona possibilità
consiste nell’analisi del contenuto azo-
tato complessivo dell’adsorbato, per
poi utilizzarlo come valore indicativo
per i composti organici. Questo risulta
composto di certo esclusivamente di
composti organici (e batteri), dato che
nitriti e nitrati non vengono schiumati.
Una analisi corrispondente del conte-
nuto di azoto nell’adsorbato di alcune
vasche sperimentali, condotta da SHI-
MEK (2002), evidenziò valori di 420-650
mg per ogni chilogrammo di adsor-
bato. Delle analisi molto interessanti
concernenti la composizione dell’ad-
sorbato sono state pubblicate da K.S.
Feldman, della Pensylvania State Uni-
versity, USA, nel suo articolo su “Advan-
ced Aquarist” comparso nel 2010 “Ele-
mental Analysis of Skimmate: What
Does a Protein Skimmer Actualy
Remove from Aquarium Water?”. La
base delle sue analisi è stato un acqua-
rio di barriera di circa 600 litri con una
definita presenza di animali (pesci e